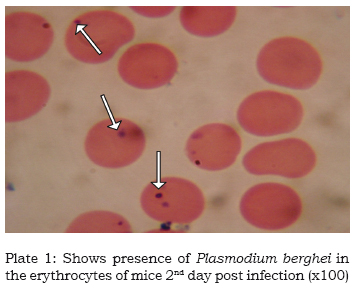

Servicios Personalizados
Revista
Articulo
Indicadores
-
Citado por SciELO -
Accesos
Links relacionados
-
Similares en
SciELO
Compartir
Revista latinoamericana de química
versión impresa ISSN 0370-5943
Rev. latinoam. quím vol.39 no.1-2 Naucalpan de Juárez 2011
In vivo antiplasmodial activity by aqueous extract of Abrus precatorius in mice
Saganuwan Alhaji Saganuwan1,*, Patrick Azubuike Onyeyili1, Egoohe George Ameh2, Emmanuel Udok Etuk3
1 Department of Veterinary Physiology, Pharmacology and Biochemistry, College of Veterinary Medicine, University of Agriculture, P.M.B .2373 Makurdi, Benue State, Nigeria. *Corresponding Author: pharn_saga2006@yahoo.com +2347039309400 +2348027444269.
2 Department of Medical Microbiology and Pathology, College of Health Sciences, Usmanu Dan Fodiyo University P.M.B. 2254 Sokoto, Sokoto State, Nigeria.
3 Department of Medical Pharmacology, College of Health Sciences, Usmanu Dan Fodiyo University P.M.B. 2254 Sokoto, Sokoto State, Nigeria.
Received July 2011.
Accepted October 2011.
ABSTRACT
Antimalarial activity of aqueous extract of Abrus precatorius leaf was studied in Swiss albino mice. Thirty-six (36) mice of either sex that weighed 20.61 ± 3.63g were separated into six groups of six mice each. Five groups were intravenously inoculated 107 Plasmodium berghei per gram body weight. The sixth group was neither infected nor treated. Three days post infection, four groups were administered orally with 25, 50 and 100mg/kg of the extract and 25mg/kg of halofantrine for five consecutive days, whereas the fifth group was not treated. The results revealed significant (P<0.05) clearance of P. berghei from the groups administered with 25, 50 and 100mg/kg of the extract, and 25mg/kg of halofatrine respectively on 14th day of infection. The infected untreated group showed significant level of parasitaemia up till 14th day of infection. There were significant (P<0.05) decreased levels of mean weight gain, mean erythrocytes count, mean packed cell volume, mean haemoglobin concentration, mean corpuscular volume and mean corpuscular haemoglobin. However, Mean corpuscular haemoglobin concentration and mean white blood cells increased significantly in infected untreated group (P<0.05). Three animals died from each of the groups treated with 25 and 100mg/kg of the extract. While one animal died from the infected untreated group and the halofantrine treated group. Hence, the extract show potential antiplasmodial activity on P. berghei ,the death of animals in the experimental groups may be due to toxicity of Abrus leaf, halofantrine and P. berghei respectively.
Keywords: Antiplasmodial activity, Abrus precatorius leaf, halofantrine, Mus musculus, Plasmodium berghei, toxicity
RESUMEN
Se estudió la actividad antimalárica del extracto acuoso de las hojas de Abrus precatorius en ratones albinos. Treinta y seis ratones de ambos sexos con peso promedio de 20,61 ± 3.63 g fueron separados en seis grupos de seis ratones cada uno. Cinco grupos fueron inoculados por vía intravenosa con 107 de Plasmodium berghei por gramo de peso corporal. El sexto grupo no fue infectado ni tratado. Tres días después, cuatro de los grupos fueron administrados con 25, 50 y 100 mg/kg de extracto, y 25 mg/kg de halofantrina, respectivamente, durante cinco días consecutivos, mientras que el quinto grupo no fue tratado. Los resultados muestran significativamente (P <0.05) la desaparición de P. berghei en los grupos administrado con dosis de 25, 50 y 100mg/kg de peso corporal del extracto, y 25 mg/kg de halofatrina a los 14 días de infección. El grupo no tratado e infectado mostró un nivel significativo de parasitemia a los 14 días de infección. La disminución de niveles de peso promedio fue significativa (P <0,05), asi como la media de recuento de eritrocitos, el volumen globular, la concentración media de hemoglobina, el volumen corpuscular medio y la hemoglobina corpuscular media. Sin embargo, la concentración de hemoglobina corpuscular y la media de los glóbulos blancos aumentaron significativamente en el grupo infectado y sin tratamiento (P <0,05). Tres animales cada grupo tratado con 25 y 100 mg/kg de extracto murieron, mientras que sólo uno murió en los grupos tratados con halofantrina y el grupo sin tratamiento. Por lo tanto, el extracto tiene una actividad antimalárica potencial para P. berghei, la muerte de animales en los grupos experimentales podría deberse a la toxicidad de las hojas de Abrus precatorius, de la halofantrina y de P. berghei.
Palabras clave: Actividad antimalarica, Abrus precatorius, halofantrina, Mus musculus, Plasmodium berghei, toxicidad.
INTRODUCTION
Abrusprecatorius, also known as jecquirity bean, is a member of papillionaceae family used (in folklore medicine) to treat diabetes, asthma (Saganuwan, 2009), chronic nephritis (Ligha, 2009), cancer (Sivakumar and Alagesaboopathi, 2008), sores, scratches, wounds, leucoderma, tetanus, boils, abscesses, for prevention of rabies (Saganuwan, 2010), with haematonic, plasma expander known effect (Saganuwan and Onyeyili, 2011), also used to treat microbial infections caused by Streptococcus pyogenes, Streptococcus pneumonia, Salmonella typhimurium, Escherichia coli and Klebsiella pneumonae (Saganuwan, 2005a,b; Adelowotan et al., 2008). Other uses of the plant are in blenorrhalgia, chest pain, diarrhoea, oliguria, emesis, constipation (Duke, 2002), convulsion and colic (Iwu, 1993). The plant has reported toxic effect on kidney, liver, heart, spleen, intestine and lungs (Saganuwan and Onyeyili, 2010). The reported phytochemical components of the plant are abricin, abrin, abrisin, abrine, abraline, abrasine, abrussic acid, anthocyanins, ash, campestrol, cycloartenol, picatorine, precasine among others (Windholz, 1983). Abrin A and abrin B agglutinins are also reported type IV ribosome inactivating proteins that inhibit protein synthesis in eukaryotes and induce apoptosis (Bagaria et al., 2006).
Infectious diseases are the world's leading cause of premature deaths, killing almost 50,000 human every day. Human malaria is the world's worst disease, which claims 2.7 - 3 million lives annually. About 1.5 billion people live in regions where malaria is endemic, including Nigeria. Malaria is responsible for 1 in 5 childhood death in Africa and at least fifty per cent of Nigerian population experience one episode of malaria every year. Also is the cause of death before the age of 5 years in 1/5 and 1/3 of children in urban and rural areas of Nigeria respectively (Akubue, 2006). Saganuwan and Adelaiye (2007) reported that those between the age range of 0 and 39 years are mostly affected by malaria in the middle belt of Nigeria. Malaria is becoming more difficult to treat because of multidrug parasite resistance. Abrus precatorius has been used by Nupes in Bida emirate of Niger State, Nigeria, for the treatment of suspected acute and chronic cases of malaria especially when the use of orthodox antimalarials might have failed. In view of this, the antiplasmodial activity of aqueous extract of Abrus precatorius leaf was studied in Mus musculus using Plasmodium berghei as the infective parasite model with a view to establishing basis for its folkloric use as an antimalarial.
MATERIALS AND METHODS
Collection of the plant materials
The plant materials (leaves) used for the study were obtained from Bida, headquarters of Bida Local Government Area of Niger State, Nigeria. The plants were collected during dry season and identified by the botanist, Mal Umaru Denge in the Department of Biological Science, Usmanu Danfodiyo University Sokoto, a specimen with voucher No. 2005029 was deposited.
Aqueous Extract of the plant materials
The leaves collected were air dried to a constant weight under open shade and pulverized with the help of a mortar and pestle to fine powder. Fifty (50) grams of Abrus precatorius leaf powder was dissolved in 1000ml of distilled water in a conical flask. The mixture was thoroughly shaken intermittently throughout the period of extraction using glass rod stirrer and allowed to stand overnight. The mixture was filtered with Whatman filter paper No.1 into a measuring cylinder, concentrated at 60°C in an incubator, and stored in a refrigerator at 4°C until required for use (Saganuwan and Gulumbe, 2005a).
Experimental Animals
A total of thirty-six (36) mice (Mus musculus) of either sex obtained from Nigerian Veterinary Research Institute (NVRI) Vom, Plateau State, Nigeria were fed with mice feed (finisher®) formulated by Grand Cereals and Oils Mills Limited (GCOML) and clean water provided ad libitum. Animals were cared according to laboratory animal care guidelines (CIOMS, 1985) and recommended procedures of the Department of Veterinary physiology and pharmacology University of Agriculture Makurdi ethical committee on the use of animals.
Plasmodium berghei
Plasmodium berghei, strain NK65 used for the study was obtained from Nigerian Institute of Medical Research (NIMR), Yaba, Lagos, Nigeria. The parasite which produced acute infections in mice with a prepatent period of 2 to 3 days, was maintained by serical passaging using one quarter milliliter of infected blood containing 107 plasmodium. The organisms were inoculated intraperitoneally and mice were examined daily for the presence of the parasites. Saganuwan et al. (2009) determined LD50 of aqueous Abrus precatorius leaves extract at a dose of 2559.5 mg/kg and selected therapeutic doses between the range of 10th and 100th of the estimated LD50. So dose levels of 25, 50 and 100mg/kg were chosen for this study.
Thirty-six (36) mice of either sex weighed 20.6 ± 3.63g screened for presence of haemoparasites and were separated into six groups of six mice each. A group served as a negative control. The remaining five groups of mice were inoculated intraperitineally, 107 Plasmodium berghei per gram body weight. On the third day of infection, three groups were treated with aqueous extract of Abrus precatorius leaf at dose levels of 25, 50 and 100 mg/kg (body weight), whereas a group was treated with halofantrine (standard drug) at dose level of 25mg/kg body weight. Another group served as infected untreated control.
The following parameters were used to assess the therapeutic activity of the extract in mice: presence of parasite in the blood film and parasite load, haematological parameters (packed cell volume, erythrocyte counts, mean corpuscular volume, mean corpuscular haemoglobin, mean corpuscular haemoglobin concentration, haemoglobin, white blood cells counts and differential leucocytes counts) and frequency of death. These parameters were measured daily for the first three days, and thereafter on the 5th, 7th, 10th and 14th, days post infection. Blood samples were obtained from the nicked tail vein of the infected mice and were examined using thick and thin blood films for parasite identification and parasitized erythrocytes count respectively (Cheesbrough, 2005).
Counting of Plasmodium berghei
Thin blood film was used for counting the parasites. The part of the film where the white cells were evenly distributed and the parasites well stained was selected. Using the oil immersion objective (x100), white blood cells were counted systematically, counting at the same time the number of parasites in each field covered. The counting was done using hard tally counter.

For the objective lenses (x100), an area of thin film, where the total number of red cells was approximately 250 per field, was selected. The total number of parasitized red blood cells in four fields were counted; assumed as 1000 red cells. The percentage value of parasitized red cells was calculated as follow:

Statistical Analysis
Data on percentage of parasitaemia and haematological parameters were expressed as mean ± standard error of mean (SEM). Multiple variable analysis of variance (MANOVA) was used to analyse the results. Pillai's trace method was used to detect the least significant difference among all the treatment groups as well as between the treatment groups and the control groups at 5% level (Zar, 2008).
RESULTS
All the mice infected with Plasmodium berghei exhibited the following signs: dullness, rough hair coat, paleness of the visible mucous membranes, weakness, diarrhoea, and thirst. Infected untreated mice showed decreased body weight whereas groups administered 25 and 100mg/kg of the extract and 25mg/kg halofantrine showed increased body weight (P < 0.05). These signs were reversed with the treatments, although three animals from each group treated with 25 and 100mg/kg of A. precatorius leaf extract died, while one animal from the infected untreated group and the group treated with of halofantrine died. The non-infected control mice showed no signs of Plasmodium berghei infection throughout the period of experimentation (Table 1).
The effect of aqueous extract of Abrus precatorius leaves on the percentage parasitized red blood cells of mice infected with Plasmodium berghei is shown in Table 2. The infected animals developed teeming parasitaemia within three days after inoculation of the parasite (plates 1). The percentage of parasitized erythrocytes in the infected untreated group was significantly higher (P<0.05) compared to the groups treated with either the various doses of the extract or the standard drug dose (halofantrine). Treatment with the extract resulted in an improvement of size and shape of parasitized erythrocytes. The levels of Plasmodium berghei in mice blood decreased on the 3rd day from 6.47 ± 0.47% [25mg/kg], 6.20 ± 0.49% [50mg/ kg] and 6.48 ± 0.57% [100mg/kg] to 0.04 ± 0.02 [25mg/kg], 0.04 + 0.02[50mg/kg] and 0.18 ± 0.03% [100mg/kg] on the 14th day respectively. Similar observations were made from the group treated with 25mg/ kg of halofantrine. On the 3rd day of infection, the percentage parasitaemia of the halofantrine treated group decreased from 6.16 ± 0.24% to 0.14 ± 0.03% on the 14th day of the experimentation (Table 2).
Table 3 shows the mean Red Blood Cells (RBC) values of mice infected with Plasmodium berghei and subsequently treated with varying doses of the aqueous extract of Abrus precatorius leaves. The preinfection mean RBC counts were similar in all the groups. Following infection, the mean RBC counts decreased and appeared to be more critical in the infected untreated group. In this later group the observed RBC decrease was significant (P<0.05) compared to the groups treated with either the extract or halofantrine. The pre-infection RBC counts of the infected untreated group were 7.49±0.20 x 1012/L on the 1st day of experimentation and at 14th day post infection it was decreased to 6.55±0.16 x 1012/L. The groups treated with either the extract or halofantrine after an initial RBC counts decrease, increased their mean RBC values at 14th day of infection, almost ranking to the RBC counts of the pre-treatment values (Table 3).
The values (Table 4) of the infected untreated control mice decreased from the 1st day with the progression of the P. berghei infection to the 14th day of infection. The decrease was significant (P<0.05) compared to the values obtained in the treated and untreated control groups which showed improved packed cell volumes. The initial haemoglobin concentrations of mice infected with P. berghei and subsequently treated with the various doses of A. precatorius leaf extract decreased significantly (P<0.05) from 13.34±0.25, 12.63±0.98, 13.70±0.21, 13.52±0.51 and 13.70±0.61g/dl to 12.08±0.40, 9.80±0.68, 11.13±0.22, 10.64±0.49 and 10.77±0.97g/dL for infected untreated, 25, 50 and 100mg/kg of the extract and 25mg/kg of halofantrine, respectively, on the 3rd day. The decrease continued until the 7th day. On the 14th day of infection, the haemoglobin values of the infected groups reversed to normal except for infected untreated groups (Table 4).
The corpuscular volume of infected untreated group decreased from pre-infection value, ranking from 50.58±1.43fL to 46.73±0.33fL on the 14th day of experimentation. But the group administered the dose of 100mg/kg of the extract had increased corpuscular volume from 47.33±0.09fL onthe first day to 53.00±4.65fL on day 14th. The pre-infection corpuscular haemoglobin (CH) and corpuscular haemoglobin concentration (CHC) of all the experimental groups of mice were comparable to the values obtained on the 14th day of experimentation; except the infected untreated group, that had significant increased CH and CHC values (P < 0.05) (Tables 4). The total white blood cells counts increased from 6.60±0.15 x 109/L on the 1st day to 7.17+0.16 x 109/L in the infected untreated group at 14th day post-infection. But groups administered 25, 50 and 100mg/kg of the extract, 25mg/ kg of halofantrine and uninfected control group had comparable values of WBC at days 0 and 14 (Table 5). However, WBC count increased on the 3rd day of infection in all mice except for the uninfected group. The differential leucocyte counts (Table 6) indicated lymphocytosis, eosinophilia and monocytosis in the infected untreated animals. But other experimental groups had comparable values of differential leucocytes count at day 0 and 14.
DISCUSSION
The present study shows that P. berghei strain Nk65 can produce within three days, parasitaemia, weakness, anaemia, diarrhoea, thirst and loss of body weight. The clinical signs observed in this study were similar to those reported in acute case of malaria infection in mice (Ajagbonna et al., 2002). The weight of the Plasmodium berghei infected untreated mice decreased significantly (P<0.05) in comparison with the weights of the infected mice treated with various doses (25, 50 and 100 mg/kg) of Abrus precatorius leaf extract and halofantrine (25 mg/kg) respectively. This shows that infection due to malaria parasite can induce significant decrease in body weight. This observation agrees with the report of Health Exchange (2001) indicating that malaria could cause decreased weight gain.
The parasitological findings show that when the condition was treated with the various doses of Abrus (25, 50 and 100 mg/kg) and halofantrine (25 mg/kg), there was an obvious decreased parasitaemia. The halofantrine treatment did not have any advantage over Abrus precatorius treatments, rather there were significant comparative decreased levels of parasitaemia in all the treated animals about the same time (on the 14th day of infection). However, the animals treated with 25 and 50 mg/kg appear to have a slight advantage over the other treatment groups; since the level of their parasitaemia was (0.04±0.02), less than those of the groups administered 100mg/kg of the extract (0.18±0.03) and halofantrine (0.14±0.03). The higher potency exhibited by 25 and 50mg/kg body weight of the extract in comparison with 100mg/kg body weight of the same extract might be due to the toxic effects of the extract on the P. berghei and at 100mg/kg the treatment response decreased probably because of therapeutic window phenomenon effect of Abrus precatorius leaf extract. The antiplasmodial potential of aqueous leaf extract of Abrus precatorius may be due to presence of secondary metabolites present in the plants, most especially alkaloids and flavonoids. Bateman and Dyson (1986) and Abdurrahman et al. (1998/1999) reported that plants contain many phytochemicals with biological activities and alkaloids and flavonoids could serve as sources of anti-malarial drugs. The death of three animals each from the group treated with 25 and 100mg/kg of the extract might be due to the toxic effect of the extract and P. berghei. Whereas the death of an animal from the group treated 25mg/kg of halofantrine may be due to toxic effect of the drug since halofantrine cause liver damage (Bennet and Brown, 2005). But the death of a mouse from the infected untreated group might not be connected with the level of parasitemia alone. Since other animals in the group survived the infection. The infected untreated control showed progressive parasitaemia until the 14th day of experimentation. But the decreased level of parasitaemia from 7.12±0.20% on the 10th day to 5.62±0.18% on the 14th day may be due to sequestration of P. berghei into liver. Some plant materials have been used for the treatment of malaria and they include quinine, an alkaloid obtained from Cinchona bark (Bateman and Dyson, 1986) and artemisinin from the plant, Artemisia annua. Awe and Makande (1991) reported the antimalarial activity of a number of African plants used to treat malaria in traditional medicine, unfortunately some of these plants show schizonticidal activity only on early infection but lack activity when the infection is already established. Bagavan et al. (2001) also reported antimalarial activity of medicinal plant extract against plasmodium falciparum. In the present study of acute malaria treatment, Abrus precatorius at dose level of 25mg/ kg was comparatively more effective than 25mg/kg halofantrine.
Abrus precatorius leaf extract is used traditionally to treat human malaria in various Nigerian communities. The observed antimalarial efficacy in the present study may be due to the presence of flavonoids, and/or other constituents of the extract. The mechanism of action of the extract in this experiment therefore may be similar to that of halofantrine, a standard antimalarial drug which induces the destruction of the asexual forms of the plasmodium parasite (Bennet and Brown, 2005). Halofantrine in this study was observed to decrease the plasmodium organisms in the infected mice at about the same rate as the extract.
The haematological findings (Tables 3 and 4) showed that the RBC, PCV and Hb levels decreased after infection with Plasmodium berghei. This is an indication of anaemia, due to haemolysis. Anaemia is a consistent finding in blood protozoan parasites infection. Some earlier investigators (Ajagbonna et al., 2002) have observed a progressive fall in RBC, PCV and Hb values in plasmodium infections. In the present study, the RBC, PCV and Hb values appear to improve with Abrus precatorius treatment on day 4 of treatment (i.e. 7 day of infection). In the group treated with halofantrine the improvement in the haematological parameters was obvious on day 10 of infection (i.e. 7 days after halofantrine treatment). The improvement in haematological parameters noticed in this study may be due to the inhibitory effect of the extract and halofantrine on the plasmodium organisms, since the increase in the blood parameters corresponded to the decreased parasites load. The MCV value (Table 4) of the infected untreated mice was decreased significantly between the 5th and 14th day indicating the presence of normocytic hypochromic anaemia, which was absent in treated, and uninfected control groups. The infected mice showed leucocytosis (Table 5), which decreased to normal range with the progressive disappearance of the parasites following treatment. The leucocytosis seen in the present study appears to be in agreement with the findings of Guyton and Hall (2007) indicating that the leucocytosis observed in the present study might be due to lymphocytosis, eosinophilia and monocytosis. The WBC counts (Table 5) and differential WBC counts (Table 6) returned to almost pre-infection levels following treatment with the extract and halo-fantrine suggesting antiplasmodial effects of aqueous extract of Abrus precatorius leaf and halofantrine. The death of 3 animals each from the group treated with 25 and 100mg/kg of the extract as well as the death of 1 each from the infected untreated and the halofantrine treated groups may be due to toxicity of Abrus leaf, halofantrine or and P. berghei.
Components of aqueous extract of Abrus precatorius leaf include tannins, saponins, flavonoids, reducing sugar, total glycosides, saponin glycosides, cardiac glycosides and alkaloids (Saganuwan and Onyeyili, 2011). Aqueous leaf extract of Abrus precatorius at dose levels of 25, 50 and 100mg/kg showed significant antiplasmodial activity against P. berghei comparable to halofantrine at dose level of 25mg/kg. The exhibited anti-plasmodial activity might be due to secondary metabolites present in the plant.
ACKNOWLEDGEMENTS
The authors thank Mr. Luka Joseph Jantiku of Federal Medical Centre Gombe, Gombe State, Nigeria for his technical assistance. Mr. Orinya Agbaji Orinya, College of Veterinay Medicine, University of Agriculture Makurdi, Benue State, Nigeria and Mr. Kehinde Ola Emmanuel, National Institute of Information Technology, Abuja would be remembered for their contributions in various capacities.
REFERENCES
Adelowotan, O., Albinu, I., Adenipekun, E, Odugbemi, T. (2008) The in vitro antimicrobial activity of Abrus precatorius (L) fabaceae extract on some clinical pathogens. Nigerian Postgraduate Medical Journal 15(1): 32-37. [ Links ]
Ajagbonna, O.P., Esaigun, P.E., Alayande, N.O., Akinloye, A.O. (2002) Anti-malarial activity and haematological effect of stem bark water extract of Nuclea latifolia. Bioscience Research Commununication 14(5): 481-486. [ Links ]
Akubue, P.I. (2006) Textbook of Pharmacology. Africana first publishers limited, Nigeria pp 603. [ Links ]
Awe, S.O., Makinde, J.M. (1991) Antimalarial effects of the stem bark aqueous extracts of three Khaya species. Fitoterapia 57: 467-473. [ Links ]
Bagaria, A., Surendranath, K., Ramagopal, U.A., Rmaumar, S., Karade, A.A. (2006) Structure-Function analysis and Insight into the reduced toxicity of Abrus precatorius agglutinin I in relation to Abrin. Journal of Biology and Chemistry 281: 34465-34474. [ Links ]
Bagavan, A., Rahuman, A.A., Kaushik, N.K., Sahal, D. (2011). In vitro antimalarial activity of medicinal plant extracts against Plasmodium falciparum. Parasitology Research 108(1): 15-22. [ Links ]
Bateman, D.N., Dyson, E. H. (1986) Quinine toxicity: Adverse drug reaction. Acute poison Review 5:215- 233. [ Links ]
Bennet, P.N., Brown, M.J. (2005) Clinical pharmacology 9th edition, Churchill Livingstone, India p. 789. [ Links ]
Cheesebrough, M. (2005). District laboratory practice in tropical countries, Part 1, low price edition, Cambridge University Press, Cambridge, UK, pp.434. [ Links ]
Council for International Organization of Medical Sciences (CIOMS) (1985). International Guiding principle for biomedical research, involving animals C/O WHO 121, Switzerland, p9. [ Links ]
Duke, J.A., Bogenschuttz-Godwin, M.J., duCellier, J., Duke, P.A.K. (2002) Handbook of medicinal herbs 2nd ed., CRC Press Boca Raton UK DC, pp. 840. [ Links ]
Guyton, A.C., Hall, J.E. (2007) Textbook of Medical Physiology 11th ed., Saunders, An imprint of Elsevier, USA p. 1116. [ Links ]
Health Exchange (2001) Facing the challenges in complex emergencies. Roll Back Malaria, p60 [ Links ]
Iwu, M.M. (1993) Handbook of African Medicinal Plants. CRC Boca Raton Ann Arbor, UK pp. 53, 347. [ Links ]
Johann-Liang, R., Albracht, R. (2003) Safety evaluations of drugs containing artemisinin derivatives for treatment of malaria. Clinical Infectious Diseases 36: 1626 -1627. [ Links ]
Ligha A., Jaja, B., Numbere, N. (2009) Protective effect of Abrus precatorius seed extract following alcohol induced renal damage. European Journal of Scientific Research 25(3): 428-436. [ Links ]
Saganuwan, A.S. and Gulumbe, M.L. (2005a). In vitro antimicrobial activities testing of Abrus precatorius cold water leaf extract on Streptococcus pyogenes and Streptococcus pneumonia. Proceedings of 2nd Annual Conference Nigerian Society for Indigenous Knowledge and Development CRUTECH, Obubra, 9th-12th Nov. pp. 93-97. [ Links ]
Saganuwan, A.S., Gulumbe, M.L. (2005b) In-vitro antimicrobial activities testing of Abrus precatorius cold water leaf extract on Salmonella typhimurium, Escherichia coli and Klebsiella pneumoniae. Journal of Science and Technology Research 4(3): 70-73. [ Links ]
Saganuwan, A.S., Adelaiye, P.O. (2007) The epidemiology of malaria in university of Agriculture Makurdi Health Centre. African Journal of Clinical Experimental Microbiology 8(3): 122-128. [ Links ]
Saganuwan, A.S. (2009) Tropical plants with antihypertensive, antiasthmatic and antidiabetic value. Journal of Herbs Species and Medicinal Plants 15(1). pp 24-48. [ Links ]
Saganuwan, A.S., Onyeyili, P.A., Etuk, E.U. (2009) Acute toxicity and haematological studies of aqueous extract of Abrus precatorius leaf in Mus musculus. Book of Abstract 2009 Africa Education Initiative Conference held between 22nd and 25th June 2009 at National Veterinary Research Institute, Vom, Plateau State, Nigeria. p. 65. [ Links ]
Saganuwan, A.S., Onyeyili, P.A. (2010) Biochemical effects of aqueous leaf extract of Abrus precatorius (Jecquirity bean) in Swiss albino mice. Herba polonica 56 (3): 63-80. [ Links ]
Saganuwan, A.S., Onyeyili, P.A. (2011) Haematonic and plasma expander effects of aqueous leaf extract of Abrus precatorius in Mus musculus. Comparative Clinical Pathology. DOI 10.1007/s00580-011-1274-8. [ Links ]
Saganuwan, A.S. and Onyeyili, P.A. (2011). Comparative toxicological effects of oral and intraperitoneal aqueous extracts of Abrus precatorius in Mus musculus. Herba polonica 57(3). [ Links ]
Sivakumar, R., Alagesaboopathi, C. (2008) Studies on cytotoxicity and antitumor screening of red and white forms of Abrus precatorius L. African Journal of Biotechnology 7(22): 3984-3988. [ Links ]
Windholz, M. (1983) The Merck Index: An Encylopaedia of Chemicals, Drugs and Biologicals, 10th ed., New Jersey, Merck and Co. Inc. USA. [ Links ]
Zar, J.H. (2008) Biostatistical Analysis. Low price ed., Person Education, India, pp 122-150. [ Links ]













